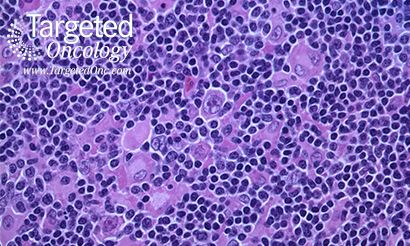

DLBCL
Latest News
Latest Videos

More News

Leonard says some of the more interesting studies to crop up in the field of Hodgkin's lymphoma include ones that utilize checkpoint inhibitors, as well as one of the first combination immunotherapies to be used in the disease

Andre Goy, MD, MS, chief, John Theurer Cancer Center's Division of Lymphoma, talks about the emerging novel therapies in diffuse large B-cell lymphoma (DLBCL).

When John P. Leonard, MD, spoke at the American Society of Hematology inaugural meeting on Hematologic Malignancies about mantle cell lymphoma (MCL), he balanced his enthusiasm about the emerging benefits that tumor profiling brings to this disease with an acknowledgement that many important questions about mantle cell lymphoma remain unanswered.

The development of novel targeted drugs, such as brentuximab vedotin (Adcentris), against discrete cell surface proteins, such as CD30, has awakened a new way of thinking about targeted cancer biology

Almost 10 years following a study that proved intraperitoneal (IP), or abdominal, chemotherapy, along with intravenous (IV) therapy, may add 16 months or more to the lives of women with ovarian cancer, less than half of these patients at US hospitals receive this type of treatment

Treatment with the PD-1 inhibitor nivolumab demonstrated durable objective response rates in patients with classical Hodgkin lymphoma, diffuse large B-cell lymphoma, and follicular lymphoma.

Catherine M. Diefenbach, MD, assistant professor, Department of Medicine, NYU Langone Medical Center, discusses the efficacy of two doses of polatuzumab vedotin (POV) in patients with relapsed/refractory (RR) follicular lymphoma (FL).

Treatment with obinutuzumab in combination with bendamustine nearly doubled progression-free survival compared with bendamustine alone in patients with rituximab-refractory indolent non-Hodgkin lymphoma.

Common AEs associated with brentuximab vedotin, such as peripheral neuropathy and neutropenia, are often manageable with modifications to dose and schedule.

Duvelisib (IPI-145) is an orally administered, dual inhibitor of phosphoinositide 3-kinase (PI3K) delta (δ) and gamma (γ) isoforms, and the drug is selective for PI3K class I isoforms over other lipid and protein kinases.

The focus in non-Hodgkin lymphoma (NHL) now needs to shift to predictive biomarkers, according to Randy Gascoyne, MD.

To gain new insight on bortezomib’s use in the frontline MCL setting, Targeted Oncology interviewed Andrew Evens, DO, MSc, director of the Tufts Cancer Center.

Although treatments and cure rates have increased significantly over the past 60 years for patients with HL, it is crucial that practitioners stay up-to-date on research that can affect outcomes for their patients with this uncommon form of cancer.

Follicular lymphoma (FL) is a slow-growing and typically asymptomatic disease, characterized by many relapses.

Experts on hematologic malignancies will convene for the 19th Annual International Congress on Hematologic Malignancies, from February 20-21 in Miami, Florida, to provide insight into recent developments in the treatment of the diseases.

The FDA has expanded the approval of ibrutinib (Imbruvica) for the treatment of patients with Waldenström’s Macroglobulinemia.

Patients with HIV-associated lymphoma can effectively be treated with autologous hematopoietic stem cell transplantation (AHCT), with outcomes that are similar to patients without HIV. Joseph Alvarnas, MD, presented results from a phase II study at the 2014 ASH Annual Meeting.

Joseph Alvarnas, MD, Director of Medical Quality, associate clinical professor, City of Hope, discusses the treatment of HIV-associated lymphoma.

Patients with relapsed and difficult-to-treat Hodgkin lymphoma who received brentuximab vedotin following treatment with high-dose chemotherapy and stem cell transplant had an unprecedented 50% higher likelihood of continuing to experience PFS at 2 years.

Marcel R.M. van den Brink, MD, PhD, Head, Division of Hematologic Oncology, Memorial Sloan Kettering Cancer Center, discusses two abstracts being presented at ASH looking at CAR T cell therapies for the treatment of ALL and NHL.

As its CAR T cell and high-affinity TCR products continue to advance in clinical trials, Juno Therapeutics, Inc, filed a registration statement for an initial public offering (IPO) of its common stock on November 17.

The landscape in lymphoma management continues to evolve, with new therapies and approaches improving established treatment paradigms.

The combination of a FLT3L-primed in situ vaccine, low-dose radiotherapy, and a TLR 3 agonist has been shown to be feasible, safe, and immunologically and clinically effective in a phase I/II study for patients with low-grade lymphoma.

Joshua Brody, MD, assistant professor, Icahn School of Medicine, director, Lymphoma Immunotherapy Program, Mount Sinai Hospital, discusses vaccine strategies in follicular lymphoma.

The FDA has approved bortezomib (Velcade) in combination with rituximab, cyclophosphamide, doxorubicin, and prednisone (VR-CAP) as a frontline treatment for patients with mantle cell lymphoma.